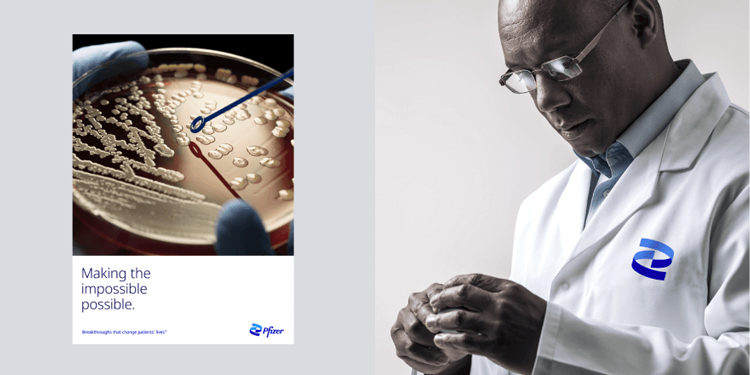

Proprio mentre ha gli occhi di tutto il mondo puntati addosso, per via del vaccino anti-Covid, Pzifer, la nota casa farmaceutica statunitense, mette in atto un’importante operazione di rinnovamento grafico del logo.
Pfizer è stata fondata a New York nel 1849 da Charles Pfizer e suo cugino Charles Erhart. Nata come azienda chimica, si è poi sviluppata nel Novecento fornendo penicillina durante la seconda guerra mondiale. Famosa, tra le altre cose, per l’invenzione del Viagra, recentemente è stata la prima azienda mondiale (in collaborazione con la tedesca BioNTech), a sviluppare il vaccino per combattere il Covid.
Proprio in un momento così importante Pfizer ha deciso di rifare il logo con una nuova immagine ispirata alla struttura ad elica del DNA. Una scelta ancor più coraggiosa se si considera che il logo era stato modificato 4 volte a partire dalla data di fondazione e, nelle ultime tre versioni, aveva visto modifiche minime.
 Il progetto di rebranding è stato condotto dall’agenzia Team di News York. Oltre a un nuovo logo, il rebrand ha compreso una revisione totale della identity. A testimonianza di ciò Albert Bourla, CEO Pfizer, ha dichiarato che questa operazione di restyling è stata promossa per mettere in luce la nuova era dell’azienda, che non si occupa più soltanto di curare le malattie, ma anche di prevenirle, da qui il logo a tema DNA.
Pfizer ha mantenuto il blu come colore fondante, che però è diventato bicolore”. Secondo lo studio di design Team, la tavolozza bicolore dimostra l’impegno di Pfizer sia per la scienza che per i pazienti. Il font è il Noto Sans, confermato per le sue caratteristiche di carattere pulito e aperto. Noto Sans è un font Google e per Pfizer rappresenta una scelta di apertura filosoficamente ed esteticamente allineato” con la sua visione aggiornata. Il carattere tipografico è stato sviluppato da Google e, secondo l’azienda farmaceutica, rappresenta apertura e internazionalizzazione.
Il progetto di rebranding è stato condotto dall’agenzia Team di News York. Oltre a un nuovo logo, il rebrand ha compreso una revisione totale della identity. A testimonianza di ciò Albert Bourla, CEO Pfizer, ha dichiarato che questa operazione di restyling è stata promossa per mettere in luce la nuova era dell’azienda, che non si occupa più soltanto di curare le malattie, ma anche di prevenirle, da qui il logo a tema DNA.
Pfizer ha mantenuto il blu come colore fondante, che però è diventato bicolore”. Secondo lo studio di design Team, la tavolozza bicolore dimostra l’impegno di Pfizer sia per la scienza che per i pazienti. Il font è il Noto Sans, confermato per le sue caratteristiche di carattere pulito e aperto. Noto Sans è un font Google e per Pfizer rappresenta una scelta di apertura filosoficamente ed esteticamente allineato” con la sua visione aggiornata. Il carattere tipografico è stato sviluppato da Google e, secondo l’azienda farmaceutica, rappresenta apertura e internazionalizzazione.
 Il progetto di rebranding è stato condotto dall’agenzia Team di News York. Oltre a un nuovo logo, il rebrand ha compreso una revisione totale della identity. A testimonianza di ciò Albert Bourla, CEO Pfizer, ha dichiarato che questa operazione di restyling è stata promossa per mettere in luce la nuova era dell’azienda, che non si occupa più soltanto di curare le malattie, ma anche di prevenirle, da qui il logo a tema DNA.
Pfizer ha mantenuto il blu come colore fondante, che però è diventato bicolore”. Secondo lo studio di design Team, la tavolozza bicolore dimostra l’impegno di Pfizer sia per la scienza che per i pazienti. Il font è il Noto Sans, confermato per le sue caratteristiche di carattere pulito e aperto. Noto Sans è un font Google e per Pfizer rappresenta una scelta di apertura filosoficamente ed esteticamente allineato” con la sua visione aggiornata. Il carattere tipografico è stato sviluppato da Google e, secondo l’azienda farmaceutica, rappresenta apertura e internazionalizzazione.
Il progetto di rebranding è stato condotto dall’agenzia Team di News York. Oltre a un nuovo logo, il rebrand ha compreso una revisione totale della identity. A testimonianza di ciò Albert Bourla, CEO Pfizer, ha dichiarato che questa operazione di restyling è stata promossa per mettere in luce la nuova era dell’azienda, che non si occupa più soltanto di curare le malattie, ma anche di prevenirle, da qui il logo a tema DNA.
Pfizer ha mantenuto il blu come colore fondante, che però è diventato bicolore”. Secondo lo studio di design Team, la tavolozza bicolore dimostra l’impegno di Pfizer sia per la scienza che per i pazienti. Il font è il Noto Sans, confermato per le sue caratteristiche di carattere pulito e aperto. Noto Sans è un font Google e per Pfizer rappresenta una scelta di apertura filosoficamente ed esteticamente allineato” con la sua visione aggiornata. Il carattere tipografico è stato sviluppato da Google e, secondo l’azienda farmaceutica, rappresenta apertura e internazionalizzazione.